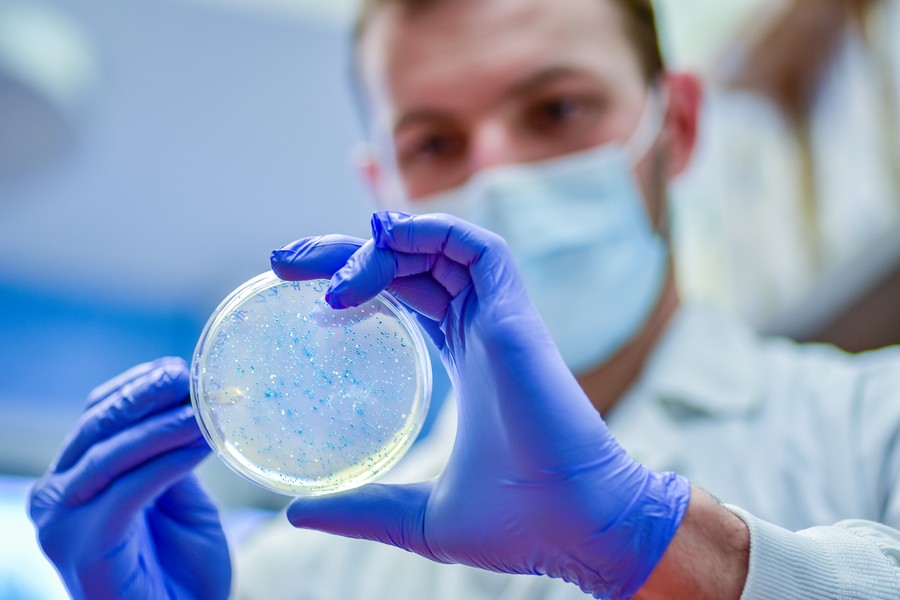

Химики Уральского федерального университета (УрФУ), работая совместно с коллегами из Индии, синтезировали новое соединение, которое демонстрирует противовоспалительную и антибактериальную активность. Ученые надеются, что это вещество может стать основой для разработки лекарств против инфекционных заболеваний, особенно тех, которые устойчивы к существующим антибиотикам.
Работа проводилась под руководством профессора кафедры органической и биомолекулярной химии УрФУ Григория Зырянова. Результаты исследований и описание синтезированных молекул были опубликованы в научном журнале Journal of Molecular Structure. Исследование получило поддержку Минобрнауки России в рамках Десятилетия науки и технологий.
Борьба с золотистым стафилококком
Новое соединение показало наилучшую активность в отношении золотистого стафилококка (Staphylococcus aureus) — наиболее агрессивного и распространенного вида, который вызывает более 60% стафилококковых инфекций. Стафилококк является видом бактерий, способным вызывать гнойно-септические процессы и оставаться жизнеспособным в различных средах до 100–200 дней.
Профессор Григорий Зырянов объяснил цель работы: «Цель нашей работы — создать эффективные вещества с небольшими побочными эффектами, к которым еще не устойчивы бактерии».
За основу нового соединения были взяты модифицированные нестероидные противовоспалительные препараты — ибупрофен и мефенаминовая кислота. К ним были добавлены фрагменты азогетероциклов, которые часто используются в разработке различных биоактивных препаратов, включая антибактериальные и противогрибковые.
Снижение побочных эффектов и два механизма действия
Ученые синтезировали восемь новых соединений, из которых два продемонстрировали хорошую активность. В основе одного из наиболее перспективных соединений лежит мефенаминовая кислота, которая, несмотря на доказанную противовоспалительную активность, используется редко из-за серьезных побочных действий. Однако химикам УрФУ удалось сохранить полезные свойства и снизить побочные эффекты, оставив только каркас молекулы и модифицировав его фрагментами азогетероциклов.
Новое соединение обладает двумя механизмами действия:
- Противовоспалительное действие: Подавляет очаги воспаления и стимулирует заживление ран. Вещество активно блокирует циклооксигеназу, что приводит к остановке синтеза простагландинов, отвечающих за развитие воспалительной реакции, отек и боль.
- Болеутоляющее действие: Воздействует на центральную нервную систему или локально на очаг воспаления.
Результаты сравнения со стандартными лекарствами
Активность синтезированных веществ была проверена на золотистом стафилококке, кишечной и сенной палочках, а также на клебсиеллах пневмонии.
Григорий Зырянов подчеркнул многообещающие результаты: «В сравнении с диклофенаком оно [новое соединение] оказывает более высокое ингибирующее действие при более низких концентрациях». Это означает, что для лечения воспалительного процесса может потребоваться меньшее количество нового препарата по сравнению с традиционными лекарствами. Кроме того, в сравнении с гентамицином — распространенным препаратом для лечения стафилококка — новое соединение показало схожую активность.
Ученые уже проверили в лабораторных условиях (in vitro и in silico) адсорбцию, токсичность, метаболизм и выведение вещества. Следующим и ключевым этапом исследований станет проверка вещества in vivo (на живых организмах).